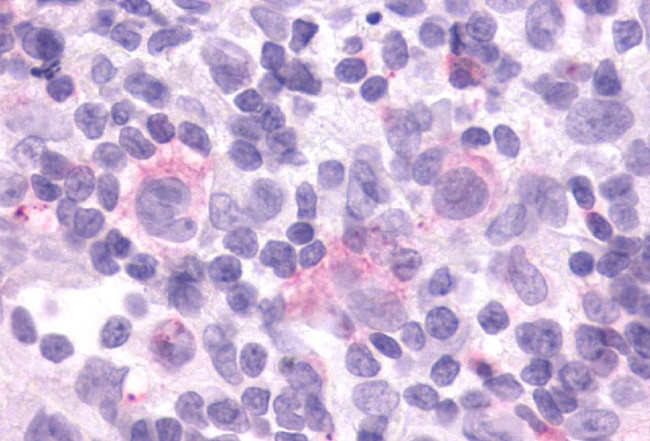
CCR9 Antibody in Immunohistochemistry (Paraffin) (IHC (P))
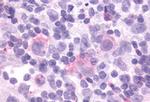
CCR9 Antibody in Immunohistochemistry (Paraffin) (IHC (P))

Search
Invitrogen
CCR9 Polyclonal Antibody
{{$productOrderCtrl.translations['antibody.pdp.commerceCard.promotion.promotions']}}
{{$productOrderCtrl.translations['antibody.pdp.commerceCard.promotion.viewpromo']}}
{{$productOrderCtrl.translations['antibody.pdp.commerceCard.promotion.promocode']}}: {{promo.promoCode}} {{promo.promoTitle}} {{promo.promoDescription}}. {{$productOrderCtrl.translations['antibody.pdp.commerceCard.promotion.learnmore']}}
产品信息
PA5-33405
宿主/亚型
分类
类型
抗原
偶联物
形式
浓度
规格
保存条件
运输条件
RRID
产品详细信息
Percent identity with other species by BLAST analysis: Human, Gorilla, Gibbon, Monkey (100%) Marmoset, Bat (88%) Sheep, Bovine, Horse, Pig, Opossum (82%).
靶标信息
The protein encoded by this gene is a member of the beta chemokine receptor family. It is predicted to be a seven transmembrane protein similar to G protein-coupled receptors. Chemokines and their receptors are key regulators of the thymocytes migration and maturation in normal and inflammation conditions. The specific ligand of this receptor is CCL25. It has been found that this gene is differentially expressed by T lymphocytes of small intestine and colon, suggested a role in the thymocytes recruitment and development that may permit functional specialization of immune responses in different segment of the gastrointestinal tract. This gene is mapped to the chemokine receptor gene cluster region. Two alternatively spliced transcript variants have been described.
仅用于科研。不用于诊断过程。未经明确授权不得转售。